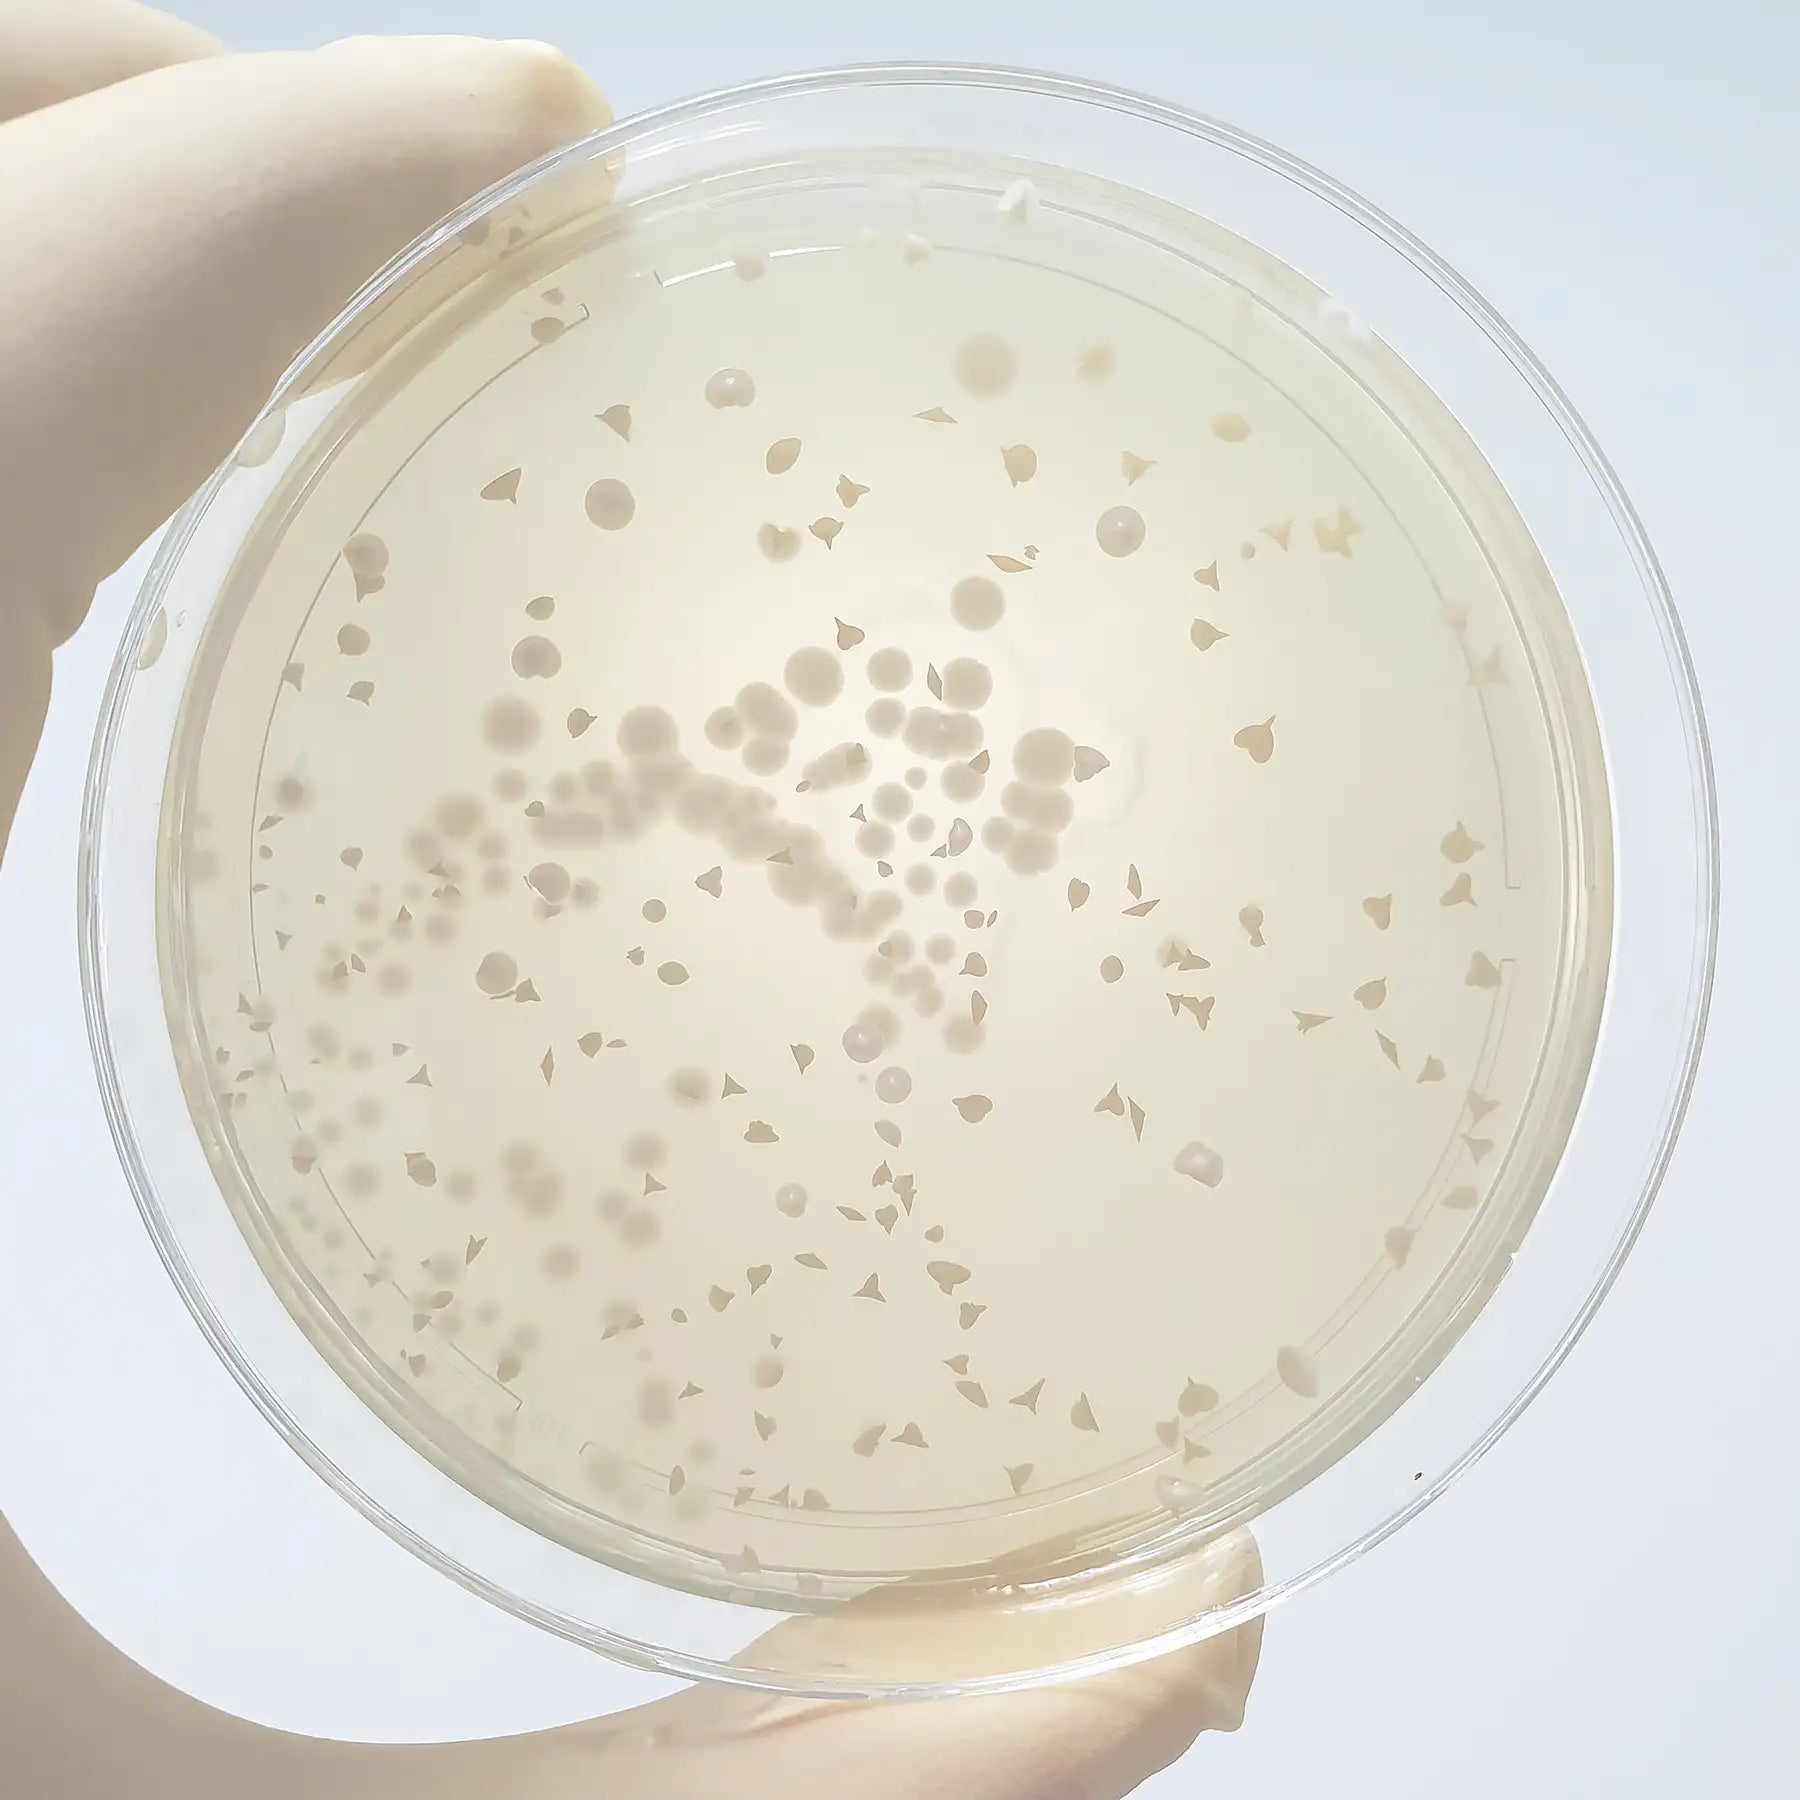

Integratori naturali
Integratori alimentari a base di piante officinali, vitamine e minerali per supportare il benessere quotidiano. Soluzioni naturali per energia, digestione, sonno, difese immunitarie, stress, metabolismo e salute di pelle, capelli e articolazioni.